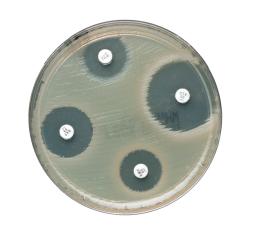
Image of the Thermo Scientific™ Oxoid™ Aztreonam-Avibactam Antimicrobial Susceptibility Discs

Thermo Scientific™ Oxoid™ Aztreonam-Avibactam Antimicrobial Susceptibility Discs
Manually determine the antibiotic susceptibility of microorganisms using disc diffusion methods with consistently reliable, industry-leading quality Thermo Scientific™ Oxoid™ Aztreonam-Avibactam Antimicrobial Susceptibility Discs

The supplier does not provide quotations for this product through SelectScience. You can search for similar products in our Product Directory.
The drug aztreonam-avibactam has been designed to address infections caused by aerobic Gram-negative organisms that are resistant to other antibiotics due to the production of beta-lactamase enzymes. Aztreonam-avibactam is especially valuable for infections caused by organisms producing metallo-beta-lactamases (MBLs), which are resistant to many other beta-lactam antibiotics.
Perform susceptibility testing of multi-drug resistant aerobic Gram-negative organisms using Aztreonam-Avibactam Antimicrobial Susceptibility Discs.
Features include:
- Meets EUCAST and CLSI recommended breakpoints
- Produces quality results in line with the rest of the Oxoid disc portfolio as demonstrated over 3 EUCAST disc quality studies
- Easy to use: shatterproof spring-loaded cartridges, easy-to-read labelling, and end-of-cartridge indicators
- Long-term stability ensured: each cartridge is individually sealed with a desiccant to maintain a moisture level of <2%
- Accurate and reproducible: manufactured under stringent quality standards including BS EN ISO 9001:2008, ISO 13485:2003 and FDA 21 CFR part 820, with comprehensive quality control testing
- Trusted supplier: over 35 years of experience in disc development and manufacture
Aztreonam-Avibactam has been shown to be effective against:
- Escherichia coli
- Klebsiella pneumoniae
- Klebsiella oxytoca
- Enterobacter cloacae complex
- Citrobacter freundii complex
- Serratia marcescens
Disc diffusion not only categorizes resistant, intermediate, and sensitive organisms through qualitative results but also provides a visual indication of the following:
- Inoculum level
- Presence of contamination
- Resistant mutants
- Beta-lactamase activity
- Antagonism and synergy between antibiotics
Thermo Fisher Scientific is a leader in providing AST solutions that help in the fight against antimicrobial resistance, offering high performance automated and manual test options and one of the largest, most up-to-date selections of antimicrobials for susceptibility testing.
Novel inhibitor combinations and susceptibility tests offer upper hand in the AMR arms race
Dr. Nathan Ledeboer highlights how new antimicrobial combos and accurate susceptibility testing are helping fight against AMR